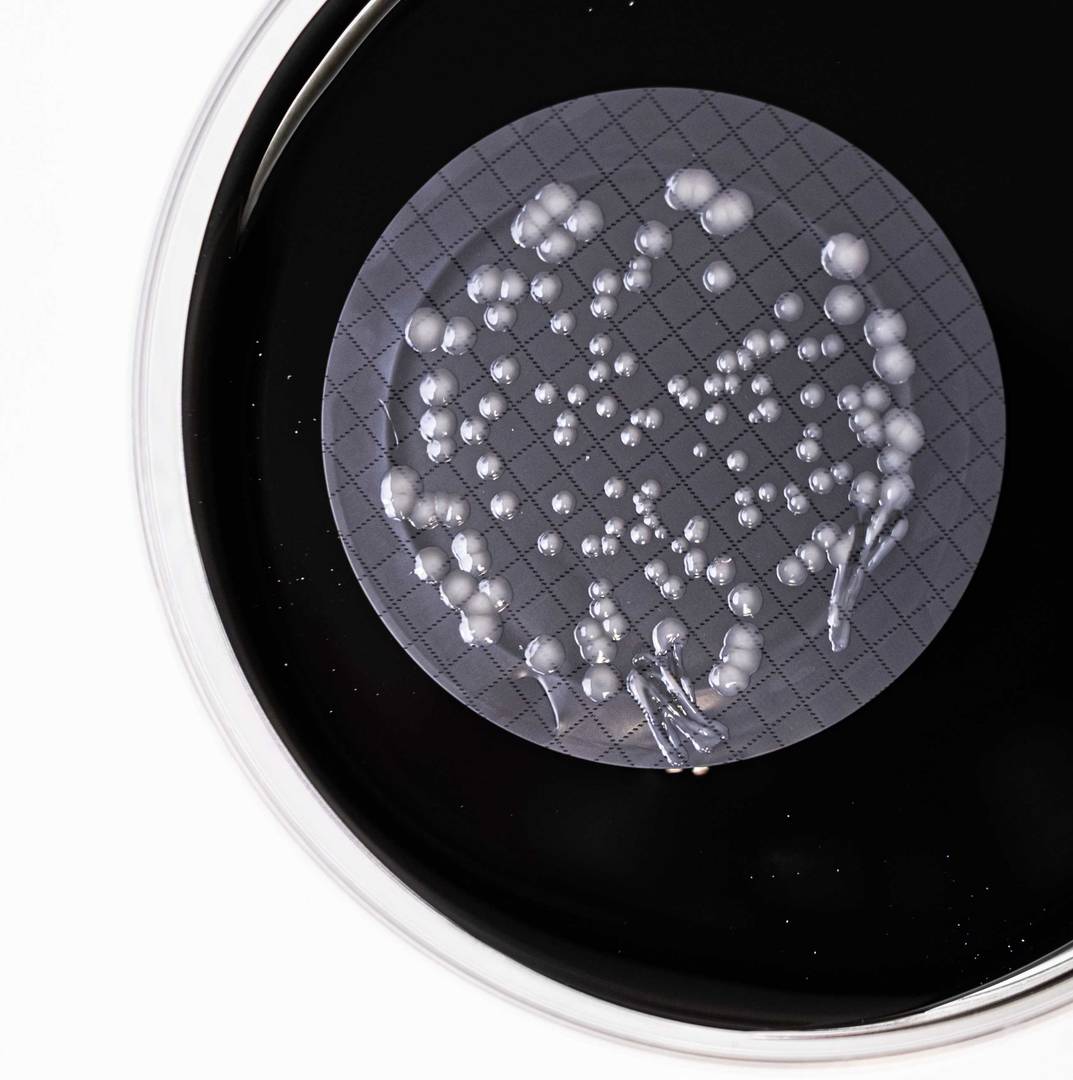
légionelles

Les légionelles dans les Tours Aéroréfrigérantes (Arrêté du 14 Décembre 2013)
Même si c’est dans l’eau potable et les Eaux Chaudes Sanitaires (ECS) que les légionelles présentent le plus grand danger pour la santé des personnes, les industriels et exploitants de Tours Aéroréfrigérantes (TAR) peuvent tout autant être touchés par la présence de légionelles dans leurs eaux.
En outre, les bactéries peuvent également proliférer dans l’eau de process, les eaux usées des industriels.
Nos experts aident les exploitants à garantir le fonctionnement de toutes les installations pour la santé des collaborateurs, locataires et clients.
L’arrêté du 14 décembre 2013 détaille les prescriptions liées à l’exploitation de TAR : La valeur limite est de < 1000 UFC/L
Les légionelles dans les Eaux Chaudes Sanitaires (ECS)
Les légionelles peuvent se développer dans les bras morts de vos installations d’eaux chaudes sanitaires (ECS) ou dans les eaux stagnantes, notamment à des températures comprises entre 25 et 45°C. Procédez à des contrôles qualité réguliers pour limiter le risque du développement de ces bactéries et vous assurer de la qualité de vos ECS.
Depuis notre laboratoire en région parisienne, nous réalisons des analyses réglementaires pour vous aider à garantir la qualité de vos eaux chaudes sanitaires et à détecter la présence éventuelle de légionelles
 Rechercher
Rechercher
 français
français
 Login
Login